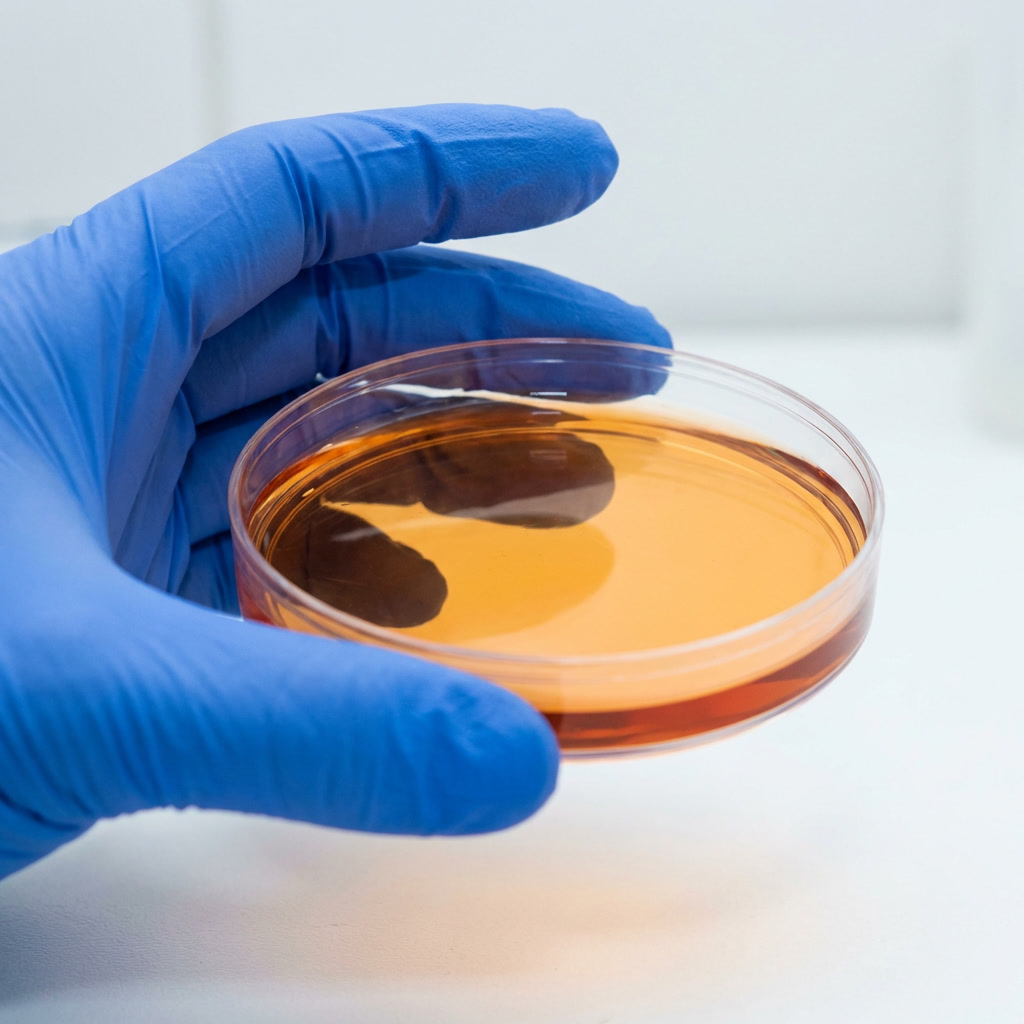
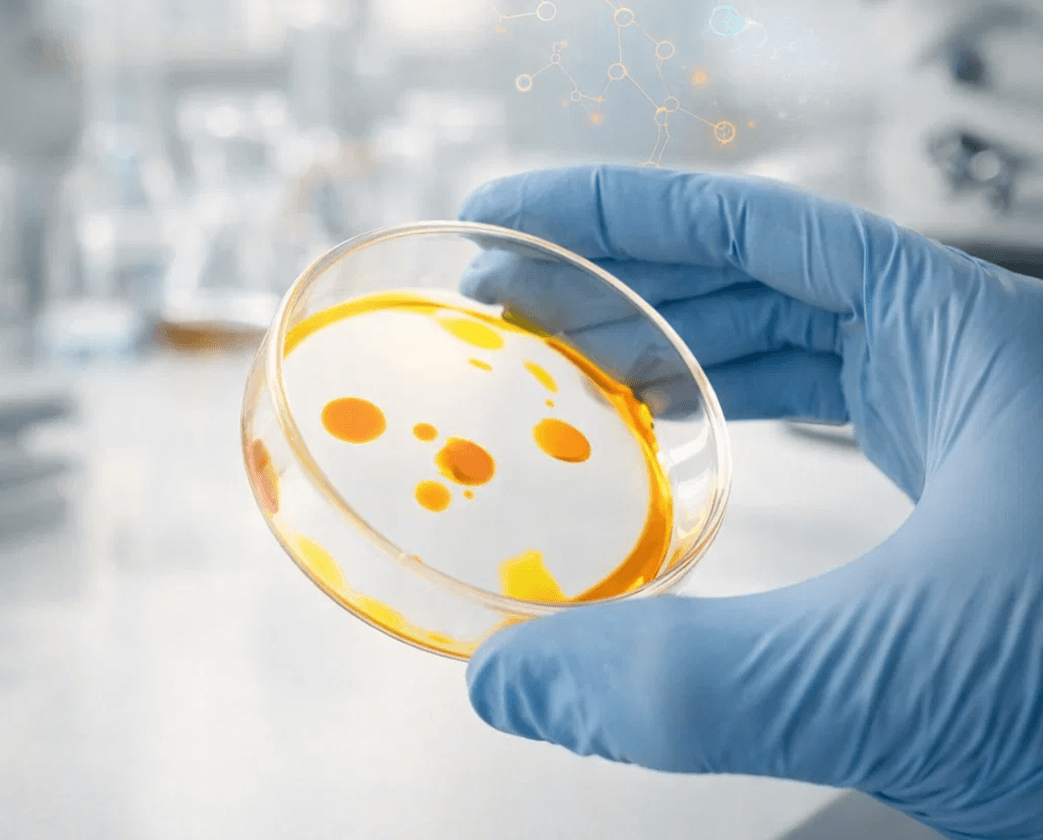

Rated 4.8/5 by 1,437+ Happy Cat Parents
Fix it naturally. Within days.

CatCalm is a line of targeted pheromone treatments for the seven biggest cat behavior problems: fighting, peeing, scratching, night chaos, stress, depression and aggression.


Rated 4.8/5 by 1,437+ Happy Cat Parents
Fix it naturally.
Within days.

CatCalm is a line of targeted pheromone treatments for the seven biggest cat behavior problems: fighting, peeing, scratching, night chaos, stress, depression and aggression.

Vet Recommended

Clinically Proven

Money-Back
Guarantee

Cruelty Free

Drug Free

Vet Recommended

Clinically Proven

Money-Back
Guarantee

Cruelty Free

Drug Free

Vet Recommended

Clinically Proven

Money-Back
Guarantee

Cruelty Free

Drug Free
Join 108,000+ cat parents
who’ve transformed their cats’ behavior with CatCalm
























































Join 108,000+ cat parents
who’ve transformed their cats’ behavior with CatCalm
























































Trusted by Veterinarians & Backed by Clinical Science
Our formulas are recommended by certified veterinary behaviorists and supported by research on feline pheromone therapy.

"PETLIFEbio's targeted approach, using specific pheromone combinations for distinct problems, mirrors best practices in veterinary behavioral medicine."
Dr. Jonathan Heyes, DVM
Board Certified Veterinary Behaviorist

"What sets PETLIFEbio apart is their commitment to science-backed formulations. I've seen remarkable improvement rates in cats with aggression, anxiety, and territory-related behaviors."
Dr. James Chen, DVM, DACVB
Certified Animal Behaviorist

"As a vet who specializes in cats, I appreciate solutions that work with feline biology rather than against it. It's elegant, effective, and completely safe."
Dr. Emily Rodriguez, DVM
Feline Specialist, 12+ Years
Trusted by Veterinarians & Backed by Clinical Science
Our formulas are recommended by certified veterinary behaviorists and supported by research on feline pheromone therapy.

"PETLIFEbio's targeted approach, using specific pheromone combinations for distinct problems, mirrors best practices in veterinary behavioral medicine."
Dr. Jonathan Heyes, DVM
Board Certified Veterinary Behaviorist

"What sets PETLIFEbio apart is their commitment to science-backed formulations. I've seen remarkable improvement rates in cats with aggression, anxiety, and territory-related behaviors."
Dr. James Chen, DVM, DACVB
Certified Animal Behaviorist

"As a vet who specializes in cats, I appreciate solutions that work with feline biology rather than against it. It's elegant, effective, and completely safe."
Dr. Emily Rodriguez, DVM
Feline Specialist, 12+ Years
What's going on in your home?

My cats fight

My cat sprays and pees
in my home

My cat bites
and scratches me

My cats are fighting

My catch scratches
on walls and furniture

My cat is stressed

My cat is restless at night
What's going on
in your home?

My cats fight

My cat sprays and pees
in my home

My cat bites
and scratches me

My cats are fighting

My catch scratches
on walls and furniture

My cat is stressed

My cat is restless at night
How CatCalm changes
your cat’s behavior at the source
Cats communicate through invisible scent signals called pheromones. When those signals are off, you see fighting, peeing, scratching, and other chaos. CatCalm uses targeted pheromone formulas to restore the signals your cat’s brain is built to follow, so behavior can change without drugs or sedation.

We create synthesised versions of the three most common cat pheromones. Instead of extracting the pheromones from cats, we replicate their molecular structure. So no cat gets ever harmed.

The pheromones then get stored in our cold-release gel beads. They contain only natural ingredients. Drug free, non-flammable and safe for cats with asthma.

All you have to do is to put the jars in areas your cats spend the most time. The gel beads release the pheromones automatically into the air.
* Demonstration. The pheromone release is invisable.
How CatCalm changes your cat’s behavior at the source
Cats communicate through invisible scent signals called pheromones. When those signals are off, you see fighting, peeing, scratching, and other chaos. CatCalm uses targeted pheromone formulas to restore the signals your cat’s brain is built to follow, so behavior can change without drugs or sedation.
We create synthesised versions of the three most common cat pheromones. Instead of extracting the pheromones from cats, we replicate their molecular structure. So no cat gets ever harmed.

The pheromones then get stored in our cold-release gel beads. They contain only natural ingredients. Drug free, non-flammable and safe for cats with asthma.

All you have to do is to put the jars in areas your cats spend the most time. The gel beads release the pheromones automatically into the air.
* Demonstration. The pheromone release is invisable.
Meet the CatCalm system for every major behavior problem

Fighting Cats?

Spraying Cat?

Aggressive Cat?

Depressed Cat?

Restless Cat?

Scratching Cat?

Stressed Cat?
Meet the CatCalm system for every major behavior problem

Fighting Cats?

Spraying Cat?

Aggressive Cat?

Depressed Cat?

Restless Cat?

Scratching Cat?

Stressed Cat?
CatCalm vs. Diffusers


Place it anywhere your cats spend time


Effectiveness
100%
~40%
Safe for cats with asthma


Clean. No oily stains on the wall.


Odorless


Non-Flammable


Specific Solutions for Specific Problems


Guaranteed Effectiveness


CatCalm
vs. Diffusers


Place it anywhere your cats spend time


Effectiveness
100%
~40%
Safe for cats with asthma


Clean. No oily stains on the wall.


Odorless


Non-Flammable


Mother Cat Pheromones (CAP)


Designed to stop cat fights


Guaranteed Effectiveness


Pheromone Types We Use For CatCalm

Mother Pheromones (CAP)
This pheromone is produced by mother cats near their mammary glands. It makes kittens feels part of the same group.

Territory Pheromones (F3)
This pheromone is produced in a cats face. It creates a sense of belonging and familiarity.

Friendship Pheromones (F4)
This pheromone is produced on a cats head. It creates a sense of trust and safety.
Pheromone Types We Use For CatCalm

Mother Pheromones (CAP)
This pheromone is produced by mother cats near their mammary glands. It makes kittens feels part of the same group.

Territory Pheromones (F3)
This pheromone is produced in a cats face. It creates a sense of belonging and familiarity.

Friendship Pheromones (F4)
This pheromone is produced on a cats head. It creates a sense of trust and safety.

Cruelty-Free
Instead of extracting pheromones from animals, we scientifically recreate the exact molecular signals cats naturally use to communicate.
These molecules are identical to those found in nature, but produced in a controlled, ethical environment.
Cruelty-Free
Instead of extracting pheromones from animals, we scientifically recreate the exact molecular signals cats naturally use to communicate.
These molecules are identical to those found in nature, but produced in a controlled, ethical environment.
Safe for your cat, safe for your wallet
You’re trusting us with your home and your cat. Here’s how we make sure that trust is never taken lightly.

30‑day money‑back guarantee
If you don’t see any meaningful change in your cat’s behavior after using CatCalm as directed, contact us within 30 days for a refund. No endless questions, no hoops to jump through.

Clinically Proven
CatCalm’s active pheromone ingredients are based on formulas that have been clinically tested for their effect on common stress‑ and conflict‑related behaviors in cats.

Vet Recommended
Our products are inspired by feline behavior science and used and recommended by vets and behavior professionals who want a non‑drug option for their patients.

Odorless
CatCalm releases invisible, scentless pheromone signals into the air. There’s no strong perfume or masking smell – most people don’t notice anything in the room.

No Effect on Humans and Other Pets
CatCalm’s pheromone messages are species‑specific. They’re designed for cats’ noses and brains, not yours – and have no known effect on humans, dogs, or other household pets.

Drug Free
CatCalm does not sedate or “knock out” your cat. It’s a drug‑free way to influence behavior by restoring the natural scent signals their brain is built to respond to.
See All Products
Safe for your cat, safe for your wallet
You’re trusting us with your home and your cat. Here’s how we make sure that trust is never taken lightly.

30‑day money‑back guarantee
If you don’t see any meaningful change in your cat’s behavior after using CatCalm as directed, contact us within 30 days for a refund. No endless questions, no hoops to jump through.

Clinically Proven
CatCalm’s active pheromone ingredients are based on formulas that have been clinically tested for their effect on common stress‑ and conflict‑related behaviors in cats.

Vet Recommended
Our products are inspired by feline behavior science and used and recommended by vets and behavior professionals who want a non‑drug option for their patients.

Odorless
CatCalm releases invisible, scentless pheromone signals into the air. There’s no strong perfume or masking smell – most people don’t notice anything in the room.

No Effect on Humans and Other Pets
CatCalm’s pheromone messages are species‑specific. They’re designed for cats’ noses and brains, not yours – and have no known effect on humans, dogs, or other household pets.

Drug Free
CatCalm does not sedate or “knock out” your cat. It’s a drug‑free way to influence behavior by restoring the natural scent signals their brain is built to respond to.
See All Products
FAQs
How long does one jar last?
One jar lasts for up to 30 days.
When will I see results?
First results will show after 3 days.
Is this safe for kittens? Multiple cats? Other pets?
CatCalm is safe for cats of all ages. It has no effect on other pets or humans.
Can I use multiple products at the same time?
Fun Lorem Ipsum text may appear in any size and font to simulate everything you create for your campaigns.
Where should I place the jar?
You should place the jars in areas your cat spends the most time. Make sure to cover all rooms your cat spends time in. Don't put the jar near heat sources or into direct sunlight, as it would speed up the evaporation of the beads.

FAQs
How long does one jar last?
One jar lasts for up to 30 days.
When will I see results?
First results will show after 3 days.
Is this safe for kittens? Multiple cats? Other pets?
CatCalm is safe for cats of all ages. It has no effect on other pets or humans.
Can I use multiple products at the same time?
Fun Lorem Ipsum text may appear in any size and font to simulate everything you create for your campaigns.
Where should I place the jar?
You should place the jars in areas your cat spends the most time. Make sure to cover all rooms your cat spends time in. Don't put the jar near heat sources or into direct sunlight, as it would speed up the evaporation of the beads.

Ready to fix your cat’s behavior for good?
CatCalm gives you targeted pheromone treatments for the biggest behavior problems – fighting, peeing, scratching, night chaos, stress and aggression. Choose the CatCalm products that match your home and give your cats a clear, natural path out of chaos and into better habits.
See All Products
Ready to fix your cat’s behavior for good?
CatCalm gives you targeted pheromone treatments for the biggest behavior problems – fighting, peeing, scratching, night chaos, stress and aggression. Choose the CatCalm products that match your home and give your cats a clear, natural path out of chaos and into better habits.
See All Products
